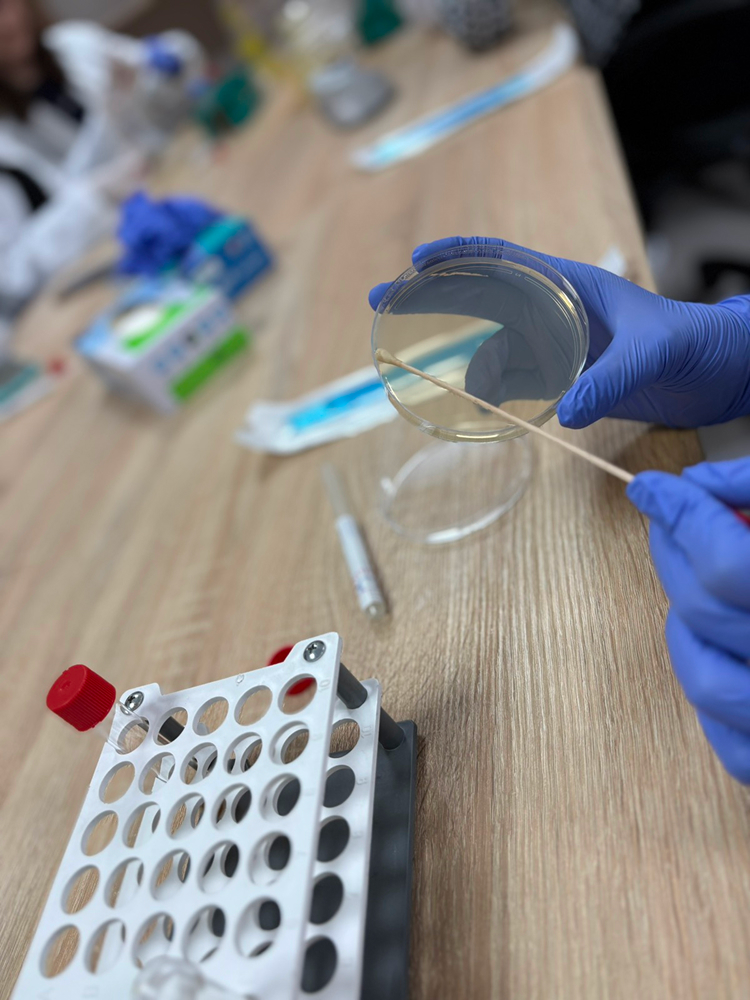
foto-09

U sklopu projekta “Biosigurnost i biozaštita u osnovnim i srednjim školama” na poziv Akademije nauka i umjetnosti Bosne i Hercegovine i Centra za kontrolu bolesti i geozdravstvene studije ANU BiH a uz suglasnost i podršku Ministarstva za odgoj i obrazovanje Kantona Sarajevo, učenici IV.a/1 razreda u pratnji prof. Matea Vukoje iz Srednje medicinske škole Katoličkog školskog centra Sarajevo posjetili su Internacionalni Burch univerzitet u Sarajevu 5. veljače 2026. godine.
Učenici su u grupama sudjelovali u različitim radionicama u svrhu edukacije o važnosti mikrobioma. U sklopu jedne od radionica u laboratoriju, zadatak je bio upoznati se sa procedurom postupanja prilikom zasijavanja bakterija na hranjivu podlogu u svrhu izolacije mikroba kao i ispitivanje antibiotskog svojstva eteričnih ulja putem antibiograma. Posebno inspirirajuće predavanje je bilo na temu “Tko je odgovoran za vaš osmijeh – bakterije ili mi sami?” gdje je fokus bio posvećen na važnost očuvanja i prevencije oralnog zdravlja. Uz novo znanje koje su stekli, učenici su se, također, veoma dobro zabavili i ujedno predložili nove ideje o realizaciji budućih školskih aktivnosti.
“Boravak na Burch univerzitetu bio je izuzetno edukativan i inspirativan, jer smo kroz stručno predavanje stekli dublje razumijevanje značaja oralnog zdravlja i njegove uloge u općem zdravlju čovjeka. Posebnu vrijednost imalo je praktično iskustvo u laboratoriji, gdje smo kroz antibiogram ispitivali antibiotska svojstva eteričnih ulja, povezujući teorijska znanja sa znanstvenim eksperimentom. Ovo iskustvo dodatno je obogatilo naše razumijevanje suvremenih pristupa u preventivnoj i eksperimentalnoj medicini” poručila je učenica Matea Radman.